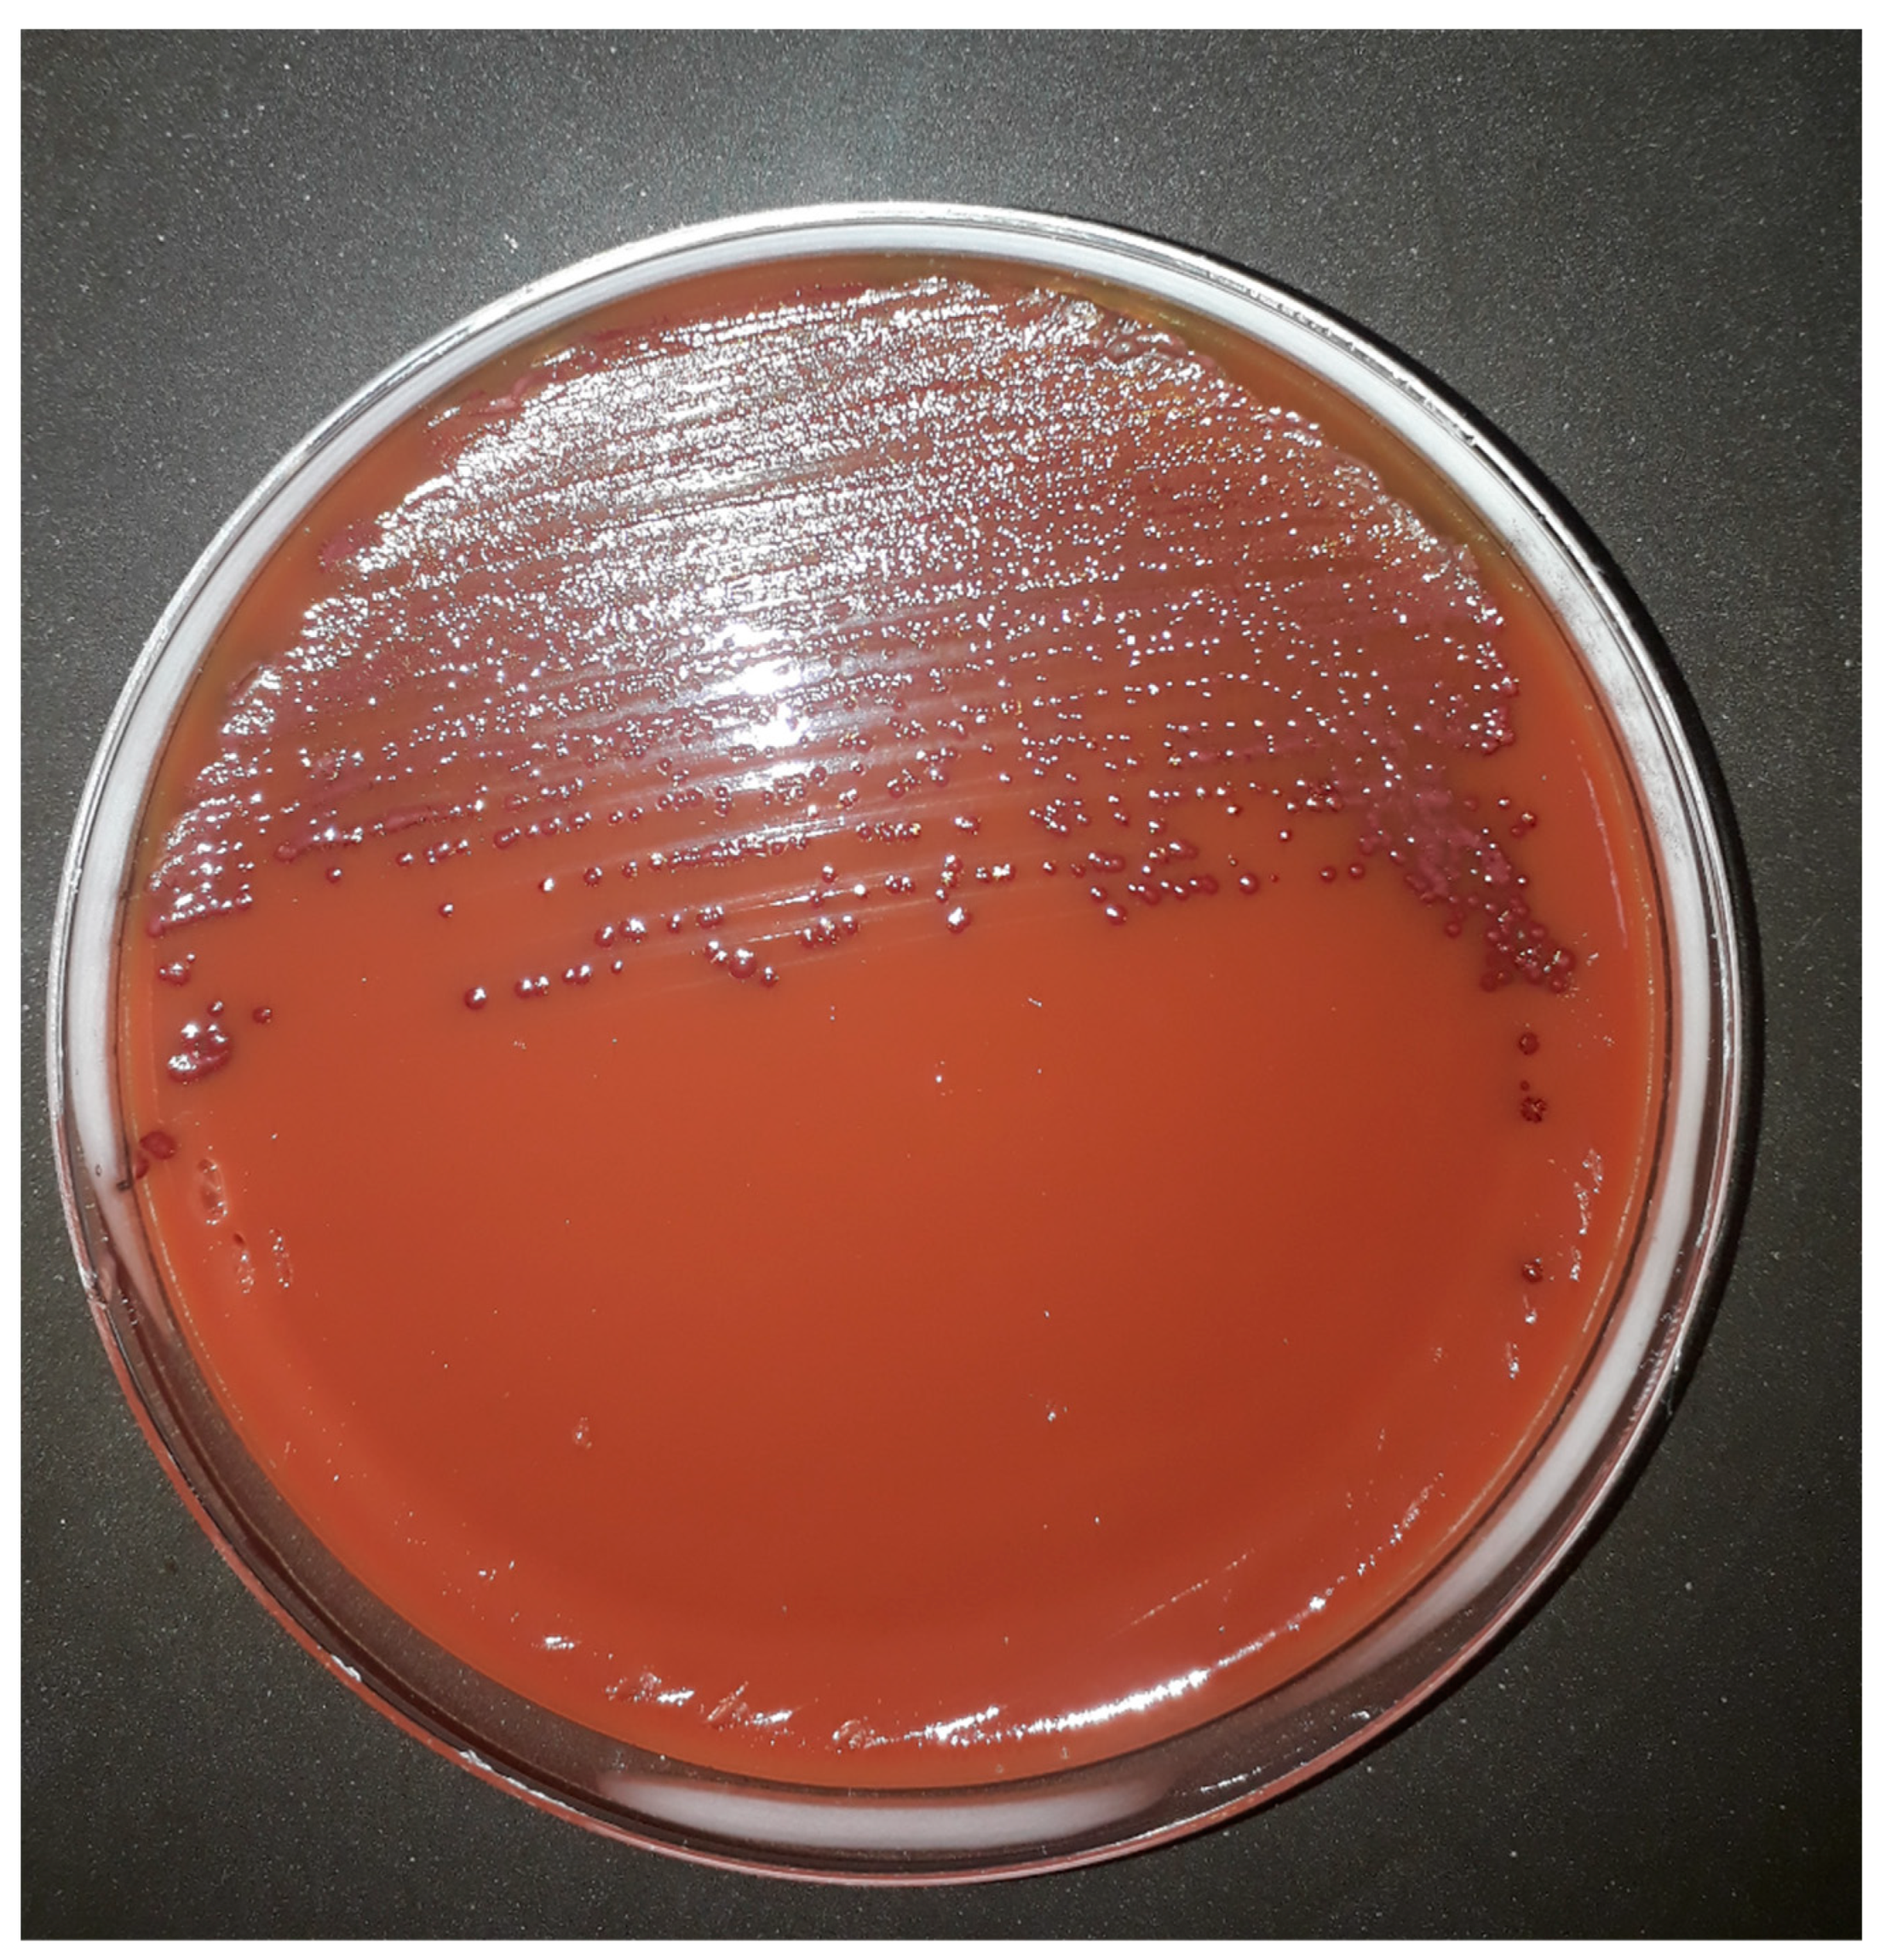
Microorganisms 10 01403 g001

CAMPYAIR, a New Selective, Differential Medium for Campylobacter spp. Isolation without the Need for Microaerobic Atmosphere
Abstract
:1. Introduction
2. Materials and Methods
2.1. Preparation of Non-Selective Basal Solid Medium
2.2. Selective Media Supplements
2.3. Campylobacter Isolates
3. Results
4. Discussion
Author Contributions
Funding
Institutional Review Board Statement
Informed Consent Statement
Data Availability Statement
Conflicts of Interest
References
- Allos, B.M. Campylobacter jejuni infections: Update on emerging issues and trends. Clin. Infect. Dis. 2021, 32, 1201–1206. [Google Scholar] [CrossRef]
- Moore, J.; Corcoran, D.; Dooley, J.; Fanning, S.; Lucey, B.; Matsuda, M.; McDowell, D.; Mégraud, F.; Millar, B.; O’Mahony, R.; et al. Campylobacter . Vet. Res. 2005, 36, 351–382. [Google Scholar] [CrossRef] [PubMed] [Green Version]
- Dasti, J.I.; Tareen, A.M.; Lugert, R.; Zautner, A.E.; Gross, U. Campylobacter jejuni: A brief overview on pathogenicity-associated factors and disease-mediating mechanisms. Int. J. Med. Microbiol. 2010, 300, 205–211. [Google Scholar] [CrossRef] [PubMed]
- Lapierre, L.; Gatica, M.; Riquelme, V.; Vergara, C.; Yañez, J.; San Martín, B.; Sáenz, L.; Vidal, M.; Martínez, M.; Araya, P.; et al. Characterization of Antimicrobial Susceptibility and Its Association with Virulence Genes Related to Adherence, Invasion, and Cytotoxicity in Campylobacter jejuni and Campylobacter coli Isolates from Animals, Meat, and Humans. Microb. Drug Resist. 2016, 22, 432–444. [Google Scholar] [CrossRef] [PubMed]
- Friedman, C.R.; Neimann, J.; Wegener, H.C.; Tauxe, R.V. Epidemiology of Campylobacter jejuni infections in the United States and other industrialzed nations. In Campylobacter; Nachamkin, I., Blaser, M.J., Eds.; American Society for Microbiology: Washington, DC, USA, 2000; pp. 121–138. [Google Scholar]
- Ondrikova, N.; Clough, H.E.; Douglas, A.; Iturriza-Gomara, M.; Larkin, L.; Vivancos, R.; Harris, J.P.; Cunliffe, N.A. Differential impact of the COVID-19 pandemic on laboratory reporting of norovirus and Campylobacter in England: A modelling approach. PLoS ONE 2021, 16, e0256638. [Google Scholar] [CrossRef] [PubMed]
- Willison, H.J.; Jacobs, B.C.; van Doorn, P.A. Guillain-Barré syndrome. Lancet 2016, 388, 717–727. [Google Scholar] [CrossRef] [Green Version]
- Toledano, J.; Saavedra-Lozano, J.; Navarro-Gómez, M.L.; Santiago-García, B.; Aguilera-Alonso, D. Severe Foodborne Bacterial Infections Mimicking Multisystem Inflammatory Syndrome in Children Associated With COVID-19. Pediatr. Infect. Dis. J. 2021, 40, e210–e211. [Google Scholar] [CrossRef] [PubMed]
- World Health Organization; Food and Agriculture Organization of the United Nations; World Organisation for Animal Health. The Global View of Campylobacteriosis: Report of An Expert Consultation, Utrecht, The Netherlands, 9–11 July 2012. 2013. Available online: https://apps.who.int/iris/handle/10665/80751 (accessed on 1 July 2022).
- Platts-Mills, J.A.; Kosek, M. Update on the burden of Campylobacter in developing countries. Curr. Opin. Infect. Dis. 2014, 27, 444–450. [Google Scholar] [CrossRef] [PubMed] [Green Version]
- Hinton, A., Jr. Growth of Campylobacter incubated aerobically in fumarate-pyruvate media or media supplemented with dairy, meat, or soy extracts and peptones. Food Microbiol. 2016, 58, 23–28. [Google Scholar] [CrossRef] [PubMed]
- Hinton, A., Jr. Aerobic growth of Campylobacter in media supplemented with C3-monocarboxylates and C4-dicarboxylates. J. Food Prot. 2013, 76, 685–690. [Google Scholar] [CrossRef] [PubMed]
- Hinton, A., Jr.; Cox, N.A. Selective Medium for Aerobic Incubation of Campylobacter. J. Food Microbiol. Saf. Hyg. 2018, 3, 131. [Google Scholar] [CrossRef]
- Line, J.E. Development of a selective differential agar for isolation and enumeration of Campylobacter spp. J. Food Prot. 2001, 64, 1711–1715. [Google Scholar] [CrossRef] [PubMed]
- Levican, A.; Ramos-Tapia, I.; Briceño, I.; Guerra, F.; Mena, B.; Varela, C.; Porte, L. Genomic Analysis of Chilean Strains of Campylobacter jejuni from Human Faeces. BioMed Res. Int. 2019, 2019, 1902732. [Google Scholar] [CrossRef] [PubMed] [Green Version]
- Miles, A.A.; Misra, S.S.; Irwin, J.O. The estimation of the bactericidal power of the blood. J. Hyg. (Lond.) 1938, 38, 732–749. [Google Scholar] [CrossRef] [PubMed] [Green Version]
- Levican, A.; Alkeskas, A.; Günter, C.; Forsythe, S.J.; Figueras, M.J. Adherence to and invasion of human intestinal cells by Arcobacter species and their virulence genotypes. Appl. Environ. Microbiol. 2013, 79, 4951–4957. [Google Scholar] [CrossRef] [PubMed] [Green Version]
- Bogosian, G.; Aardema, N.D.; Bourneuf, E.V.; Morris, P.J.; O’Neil, J.P. Recovery of hydrogen peroxide-sensitive culturable cells of Vibrio vulnificus gives the appearance of resuscitation from a viable but nonculturable state. J. Bacteriol. 2000, 182, 5070–5075. [Google Scholar] [CrossRef] [PubMed] [Green Version]
- Wang, X.; Perez, E.; Liu, R.; Yan, L.J.; Mallet, R.T.; Yang, S.H. Pyruvate protects mitochondria from oxidative stress in human neuroblastoma SK-N-SH cells. Brain Res. 2007, 1132, 1–9. [Google Scholar] [CrossRef] [PubMed] [Green Version]
- Stahl, M.; Butcher, J.; Stintzi, A. Nutrient acquisition and metabolism by Campylobacter jejuni. Front. Cell. Infect. Microbiol. 2012, 2, 5. [Google Scholar] [CrossRef] [PubMed] [Green Version]
- Guccione, E.J.; Kendall, J.J.; Hitchcock, A.; Garg, N.; White, M.A.; Mulholland, F.; Poole, R.K.; Kelly, D.J. Transcriptome and proteome dynamics in chemostat culture reveal how Campylobacter jejuni modulates metabolism, stress responses and virulence factors upon changes in oxygen availability. Environ. Microbiol. 2017, 19, 4326–4348. [Google Scholar] [CrossRef] [PubMed] [Green Version]
| Concentration of agar-agar | |||||
| 2.0% | 1.5% | 1.0% | BA (control) | ||
| Aerobic | 2+/2+/1+ | 2+/2+/2+ | 2+/2+/2+ | NG | |
| Microaerobic | 3+/3+/3+ | 3+/3+/3+ | 3+/3+/3+ | 3+/3+/3+ | |
| Concentration of starch | |||||
| 2.0% | 1.0% | 0.5% | 0.25% | BA (control) | |
| Aerobic | 1+/NG/1+ | 2+/2+/1+ | 2+/2+/1+ | NG/1+/1+ | NG |
| Microaerobic | 3+/3+/3+ | 3+/3+/3+ | 3+/3+/3+ | 3+/3+/3+ | 3+/3+/3+ |
| Concentration of Sodium deoxycholate | |||||
| 0.2% | 0.1% | 0.05% | 0.025 | BA (control) | |
| Aerobic | 1+/NG/1+ | 3+/2+/3+ | 2+/2+/1+ | 2+/1+/1+ | NG |
| Microaerobic | 3+/3+/3+ | 3+/3+/3+ | 3+/3+/3+ | 3+/3+/3+ | 3+/3+/3+ |
| Strain | Species | BA/Microaerobic | CAMPYAIR/Aerobic |
|---|---|---|---|
| ATCC 33560T | C. jejuni | 3.5 × 108 9.0 × 108 1.0 × 108 | 2.0 × 109 3.0 × 108 3.0 × 108 |
| DSM 4689T | C. coli | 1.8 × 108 4.2 × 108 1.2 × 108 | 1.2 × 109 3.1 × 108 2.2 × 108 |
| Strain | Species | CAMPYAIR/Aerobic | BA/Microaerobic |
|---|---|---|---|
| DSM 4688T | C. jejuni | 3+/3+/3+ | 3+/3+/3+ |
| DSM 4689T | C. coli | 3+/2+/3+ | 3+/3+/3+ |
| TM-PUCV 1 | C. jejuni | 3+/3+/3+ | 3+/3+/3+ |
| TM-PUCV 2 | C. jejuni | 3+/3+/3+ | 3+/3+/3+ |
| TM-PUCV 3 | C. jejuni | 3+/3+/3+ | 3+/3+/3+ |
| TM-PUCV 4 | C. jejuni | 3+/3+/3+ | 3+/3+/3+ |
| TM-PUCV 5 | C. jejuni | 3+/3+/3+ | 3+/3+/3+ |
| TM-PUCV 6 | C. jejuni | 3+/3+/3+ | 3+/2+/3+ |
| TM-PUCV 7 | C. coli | 3+/3+/3+ | 3+/3+/3+ |
| TM-PUCV 8 | C. coli | 3+/3+/3+ | 3+/3+/3+ |
| TM-PUCV 9 | C. jejuni | 3+/3+/3+ | 3+/3+/3+ |
| TM-PUCV 10 | C. jejuni | 3+/2+/3+ | 3+/3+/3+ |
| Antibiotic Formulation | |||||
|---|---|---|---|---|---|
| CCDA | CCDA + 10 μg/L Van | CCDA + 20 μg/L Van | Skirrow | BA/Aerobic | |
| DSM 4688T | 3+/3+/3+ | 3+/3+/3+ | 3+/3+/3+ | NG | |
| DSM 4689T | 3+/3+/3+ | 3+/3+/3+ | 3+/2+/3+ | NG | |
| TM-PUCV 1 | 3+/3+/3+ | 3+/2+/3+ | 3+/2+/3+ | NG | |
| E. coli | NG | NG | NG | NG | 3+/3+/3+ |
| P. aeruginosa | NG/1+/NG | NG | NG | NG/1+/NG | 3+/2+/3+ |
| S. aureus | 1+/1+/NG | NG | NG | NG | 3+/3+/3+ |
Publisher’s Note: MDPI stays neutral with regard to jurisdictional claims in published maps and institutional affiliations. |
© 2022 by the authors. Licensee MDPI, Basel, Switzerland. This article is an open access article distributed under the terms and conditions of the Creative Commons Attribution (CC BY) license (https://creativecommons.org/licenses/by/4.0/).
Share and Cite
Levican, A.; Hinton, A., Jr. CAMPYAIR, a New Selective, Differential Medium for Campylobacter spp. Isolation without the Need for Microaerobic Atmosphere. Microorganisms 2022, 10, 1403. https://doi.org/10.3390/microorganisms10071403
Levican A, Hinton A Jr. CAMPYAIR, a New Selective, Differential Medium for Campylobacter spp. Isolation without the Need for Microaerobic Atmosphere. Microorganisms. 2022; 10(7):1403. https://doi.org/10.3390/microorganisms10071403
Chicago/Turabian StyleLevican, Arturo, and Arthur Hinton, Jr. 2022. "CAMPYAIR, a New Selective, Differential Medium for Campylobacter spp. Isolation without the Need for Microaerobic Atmosphere" Microorganisms 10, no. 7: 1403. https://doi.org/10.3390/microorganisms10071403
APA StyleLevican, A., & Hinton, A., Jr. (2022). CAMPYAIR, a New Selective, Differential Medium for Campylobacter spp. Isolation without the Need for Microaerobic Atmosphere. Microorganisms, 10(7), 1403. https://doi.org/10.3390/microorganisms10071403

